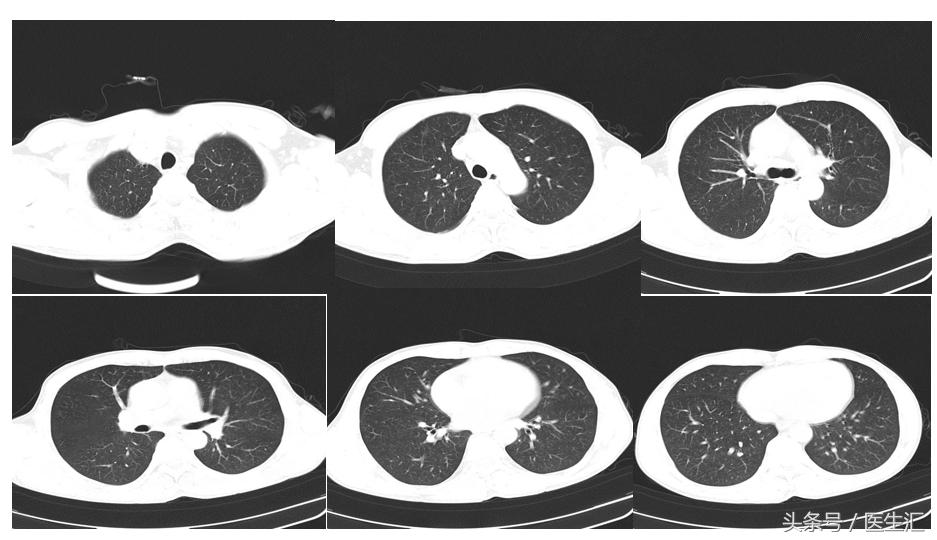
不小心吸入水泥粉末怎么办,吸入水泥粉末怎么办

基本资料:患者男性,48岁,水泥厂工人
主诉:吸入水泥粉末6天
既往病史:肝炎病史,吸烟史20*10=200年*支,饮酒史每日半斤,共10余年
既往用药史:无
现病史:6天前工作时不慎被水泥粉末掩埋约几分钟左右,期间有吸入水泥粉尘,有意识障碍,于当地医院急诊,查胸片未见明显异常,予相关治疗后患者清醒,诉眼痛,咳嗽咳痰,咳出一水泥块,大小如葵花籽,并咯血一次,鲜红色,量不多。无畏寒发热,无恶心呕吐,遂转入我院急诊予对症治疗后咳嗽咳痰症状缓解,痰中可见褐色物。现为进一步治疗入院。病程中患者无胸痛,时有胸闷,无腹痛腹泻。
体格检查•T37.4℃,P90次/分,R16次/分,BP120/65mmHg。神志清,精神萎,发育正常,步入病房,体位自主,言语清晰,查体合作。全身皮肤粘膜无黄染及出血点,右侧颈部可扪及一肿大淋巴结,大小如米粒,余浅表淋巴结未触及肿大。结膜略充血,无水肿,双侧瞳孔等大等圆,对光反射灵敏。口唇指端无紫绀。颈静脉无怒张,气管居中。双侧胸廓对称,两肺呼吸音粗,未闻及明显干湿罗音。心率90次/分,各瓣膜区未及杂音。腹平软,无压痛反跳痛,肝脾肋下未及,移动性浊音(-),肠鸣音正常。肝肾区叩击痛(-)。脊柱四肢无畸形,双下肢无水肿。生理反射存在,病理反射未引出。
辅助检查
血常规示WBC:12.6×109/L,NE:95.0% 。生化:ALT:61,AST:54 。ESR:24。CRP:14。血气分析:PH:7.36,PO2:74mmHg, PCO2:41mmHg。头颅CT示1. 颈椎轻度退变 2. 未见明显异常。视力正常,眼底检查无异常 。肺功能:FEV1、FVC正常
胸部CT

初步诊断:吸入性损伤